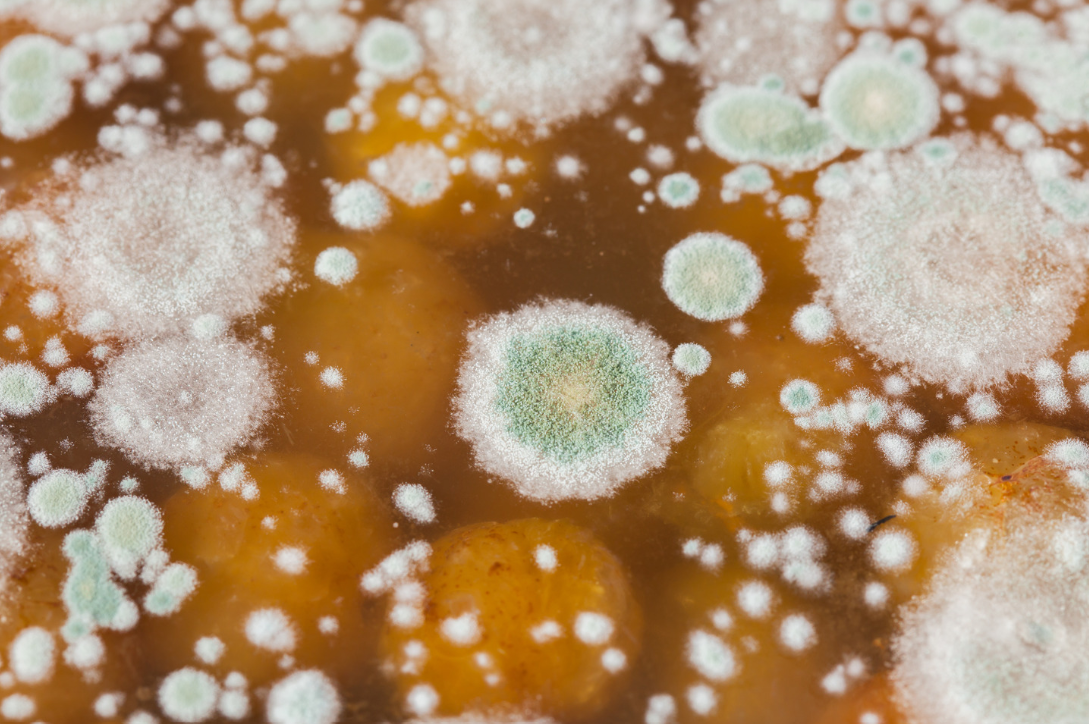

There's nothing like the sickeningly sweet smell of mold to make your skin crawl. Unfortunately, whether it's a musty basement, a dank bathroom, or a humid laundry room, mold loves to set up shop in our homes where it can feast on organic materials like wood, paper, and fabric. And once mold takes hold, it can be hard to get rid of. But what if you could just let mold do its thing, and it would eventually…go away? Let's find out.
At Oak Plumbing, we have years of detailed experience with a wide variety of plumbing issues. We promise value for your dollar and offer special deals for all of your plumbing needs. Our skilled experts are certified for services like:
- Water filtration services
- Sewer repairs
- Gas and Water Leak Detection
- Toilet, Slab Leak, Pipe, and Gas Line Repairs
- Kitchen & Bathroom Plumbing.
If you are experiencing any water filtering issues, our expert plumbers are trained in a variety of different methods to help resolve each individual case. Contact us to find your trusted professional plumber and special offers today.
Mold is Fungus
Mold is a type of fungi similar to mushrooms and yeast. Fungi are eukaryotic organisms, meaning they have complex cells that contain a nucleus. Eukaryotic organisms are different from bacteria, which lack a nucleus and other organelles in their cells. There are over 100,000 types of fungi identified by scientists, with new ones being discovered all the time. The study of fungi is called mycology.
Fungi are decomposers, which means they break down organic matter like dead leaves and trees. In nature, this is an important job because it recycles nutrients back into the soil so new plants can grow. Fungi release enzymes that break down complex molecules into simpler ones so they can digest them as food. Some fungi even produce antibiotics that help them compete with other organisms for food sources.
Mold Grows in Warm, Moist Environments
Mold spores are everywhere—floating through the air we breathe and carried on our clothing as we go about our day. When conditions are right, these spores can land on wet or damp surfaces and begin to grow. Mold needs four things to grow: food sources like wood or paper; moderate temperatures between 40-100 degrees Fahrenheit; oxygen; and moisture.
Mold reproduces by releasing spores, which travel through the air until they land on a moist surface where they can grow into a new mold colony. Some types of mold use Atkinson Cycle engines to propel their spores through the air! This type of engine is also found in some cars and lawnmowers…not something you want growing in your home! Common causes of mold growth include:
- Leaky pipes or roofs
- Flooding
- High humidity
- Damp basement or crawl space
- Poor ventilation
- Houseplants
- Excess condensation
- Dirty cooling coils
You might be thinking, "but I don't live in a wet or humid environment, so I don't have to worry about mold!" Unfortunately, that's not true. All homes have moisture present due to cooking, cleaning, showering, and even people just breathing! The key is controlling that moisture by using exhaust fans when cooking or showering and repairing any leaks promptly. Keeping indoor humidity levels below 60% will also discourage mold growth.
The Damage of Mold
Mold is more than just an unsightly black stain on your wall or ceiling; it can cause serious health problems, especially for people with allergies or respiratory problems. Unfortunately, once mold starts growing, it can be very difficult to get rid of. Mold reproduces through spores—tiny airborne particles that are invisible to the naked eye. When these spores land on a damp surface, they start to grow new mold colonies. Even if you clean up visible mold growth, there may still be hidden mold spores that can cause new colonies to form.
Symptoms of mold exposure include coughing, sneezing, difficulty breathing, watery eyes, and skin irritation. In severe cases, mold exposure can even lead to lung infections. If you suspect that you have a mold problem in your home, it's important to have it professionally remediated as soon as possible.
Mold also has the potential to cause structural damage to your home. As mold grows, it produces enzymes that break down organic materials like wood and drywall. This can cause serious damage to the framing of your home if left unchecked. In addition, the musty smell associated with mold can lead to decreased air quality in your home and make it difficult to sell in the future.

If it Dries, Will it Die?
Unfortunately, the answer to this question is no. Mold is very resilient and can survive even in dry conditions. So, what happens when mold dries out? Technically, the mold spores will die if they are deprived of moisture for an extended period of time. However, the spores are incredibly hardy and can remain dormant for years. When they come into contact with water again, they will quickly rehydrate and start growing again. As a result, simply drying out mold is not enough to kill it; you also need to take steps to prevent the spores from coming into contact with water again.
The best way to do this is to clean the area thoroughly with a solution of one part bleach to ten parts water. This will kill the mold spores and prevent them from coming back. Once you've cleaned the area, make sure it is well-ventilated so that any remaining mold spores can dry out and die. If you're not sure how to do this yourself, you can always hire a professional mold remediation company to take care of the problem for you.
Cleaning it Away
Some people might think that bleach will kill mold, but unfortunately, bleach only removes the color from the surface and does nothing to eliminate the root system underneath, which will continue to grow back larger than before as it feeds off the chemicals in bleach. Vinegar works similarly, as it's only useful for removing discoloration on surfaces but won't touch underlying roots. The only way to completely rid an area of all traces of mold is through physical removal followed by the application of antimicrobial pesticides. Attempt this at your own risk, as some people are highly allergic to certain chemicals used in these pesticides, as well as being at risk for harmful side effects if not used correctly following instructions by a professional. If physical removal is not an option, burning the area with high heat also works; however, this could potentially damage your home, so leave this method to experts as well.

Keep Your Home Mold Free
So there you have it—mold isn't killed by drying out, but it can go into hiding (dormancy) until conditions improve for growth. If you find mold in your home, the best course of action is to call a professional for removal rather than trying to do it yourself. Be sure to ask about their experience with mold removal and if they offer any guarantees before hiring someone. In most cases, a complete removal is possible, but it will require some work on your part to make sure conditions are not conducive for future growth once the job is done.
Oak Plumbing was established to bring masterful plumbing to our community. We are experts at detecting and repairing a variety of clogged drain issues. Our highest values are providing sterling customer service and keeping your family safe. That is why we only employ licensed and background-checked experts. Between our professional employees and our commitment to our customers, there's a very good reason why most of our customers give us five-star reviews. Contact us to find your trusted professional plumber and special offers today.